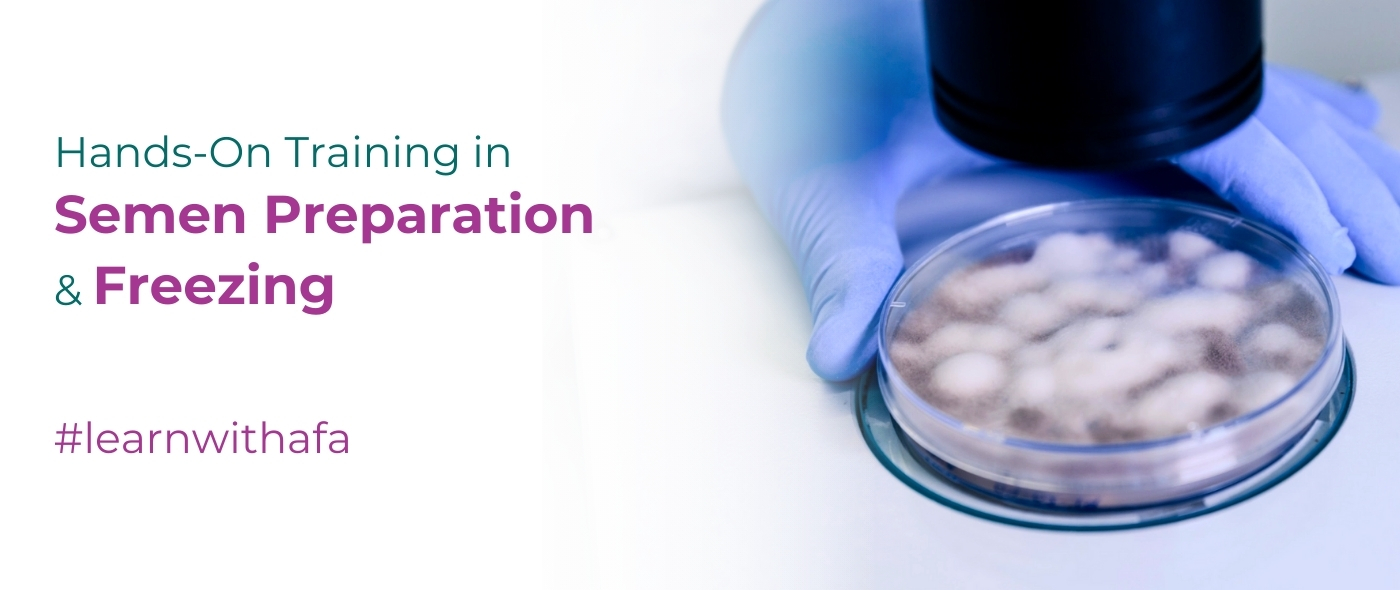

Practical Training in Semen Processing & Cryopreservation Techniques
The Semen Preparation & Freezing (Hands-On Training) program is an intensive 2-week practical course designed for professionals who want focused, real-time laboratory experience in semen preparation techniques and sperm cryopreservation used in IVF and fertility laboratories.
This short-term course emphasizes hands-on training, standard protocols, and clinical relevance, making it ideal for upgrading skills in andrology and ART labs.
Course Details
-
Duration: 2 Weeks
-
Batch Start: 1st of Every Month
-
Timings: 10:00 AM – 2:00 PM
-
Course Fee: ₹50,000
What You Will Learn (Hands-On Focus)
Semen Preparation Techniques
-
Sample handling & processing protocols
-
Swim-Up technique
-
Density Gradient Centrifugation (DGC)
-
Selection of sperm for IVF & ICSI
-
Quality assessment before and after preparation
Semen Freezing & Cryopreservation
-
Basics of sperm cryobiology
-
Cryoprotectants & freezing media
-
Step-by-step semen freezing protocols
-
Storage & liquid nitrogen handling
-
Thawing procedures & post-thaw evaluation
Key Highlights
-
100% hands-on laboratory training
-
Focus on IVF & ART lab protocols
-
Practical exposure to freezing & thawing techniques
-
Small batches for personalized learning
-
Ideal skill-upgrade program for working professionals
Who Should Enroll?
-
Andrology Lab Technicians
-
IVF & Fertility Clinic Staff
-
Embryology & Andrology Students
-
Life Science Graduates
-
Professionals seeking short-term IVF lab training
Career & Skill Benefits
-
Enhanced expertise in semen processing
-
Practical knowledge of sperm cryopreservation
-
Improved competency for IVF & ART labs
-
Valuable add-on certification for fertility professionals
Why Choose This Program?
-
Short-duration, high-impact training
-
Industry-relevant IVF lab skills
-
Monthly batch availability
-
Hands-on learning with real lab exposure
Enroll Now – Semen Preparation & Freezing (Hands-On)
👉 Limited Seats | Register Now